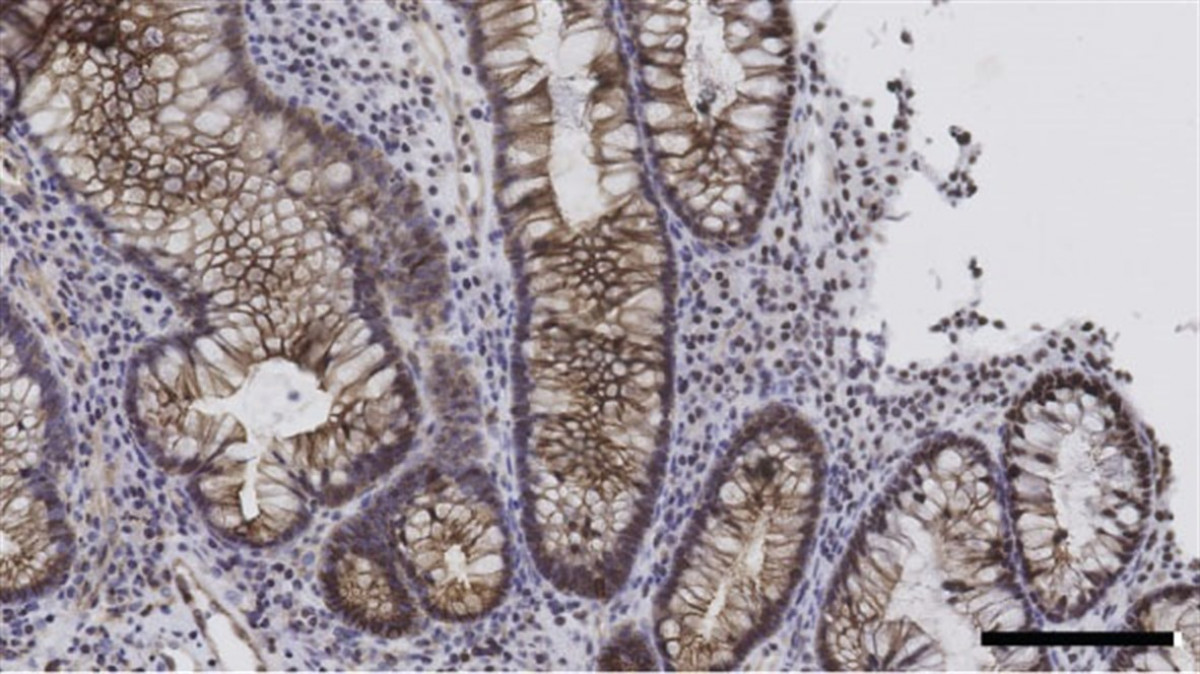

Investigadores catalanes descubren un método para reducir tumores de colon
La investigación, liderada por científicos del Institut de Recerca Biomèdica de Barcelona (IRB), ha demostrado que la inhibición genética de la hormona IGF-1 tiene efectos beneficiosos en los enfermos de cáncer de colon.

Científicos del Institut de Recerca Biomèdica de Barcelona (IRB), liderados por el investigador Angel R. Nebreda, han demostrado que la inhibición genética o farmacológica de la hormona IGF-1 suprimiría el reclutamiento de células inflamatorias y reduciría los tumores de colon asociados a inflamación.
Publicada en la revista 'EMBO Molecular Medicine', la investigación se ha llevado a cabo utilizando modelos de inflamación aguda y crónica en ratones modificados genéticamente o tratados con inhibidores farmacológicos.
"Demuestra que la capacidad de las células mieloides para promover la tumorigénesis depende de la proteína p38, e identificamos una contribución importante de la hormona IGF-1", ha detallado Nebreda este miércoles en un comunicado.
Apunta que, centrando la inhibición en la hormona IGF-1, "se podría ayudar a superar el poco éxito que están teniendo los inhibidores farmacológicos p38 en los ensayos clínicos con pacientes que están predispuestos al cáncer de colon".
"Nos permite sugerir que las decisiones terapéuticas deberían considerar las condiciones inflamatorias y los niveles de IGF-1 en biopsias de pacientes con enfermedad inflamatoria intestinal o colitis asociada a cáncer", concluye.
El trabajo se ha llevado a cabo con la colaboración de investigadores del Centro Nacional de Investigaciones Oncológicas (CNIO) y el Hospital Ramón y Cajal de Madrid, entre otras instituciones.

Escribe tu comentario